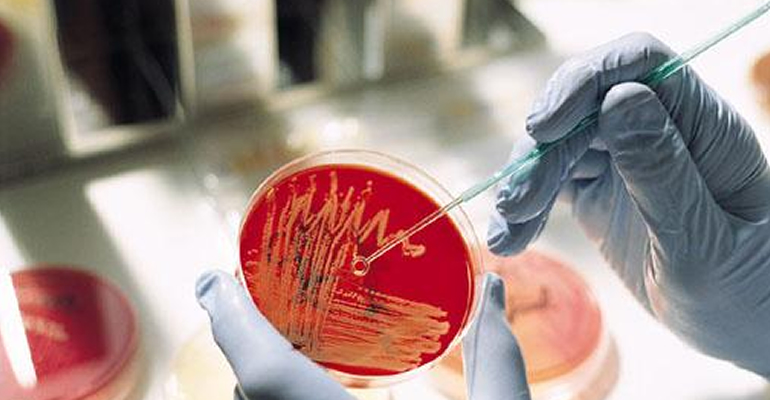

Laboratory Services
We have one of the most up-to-date laboratories in the region. We are proud to say that our laboratory is accredited by the South African National Accreditation Services (SANAS) to offer testing in various areas: Water, Food products and Hygiene swabs.
Our state-of-the-art facility is run by competent and well-trained personnel, with vast experience in the laboratory management.
